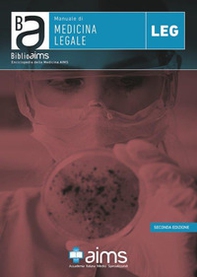
Manuale di medicina legale - Librerie.coop

Per gli acquisti online: spese di spedizione gratuite da 25€ - Per i soci Coop o con tessera fedeltà Librerie.coop gratuite a partire da 19€.
Accademia It. Medici Spec.
MIGLIORA LA TUA RICERCA
FORMATO
CATEGORIA
PREZZO
- da € 0.00 a € 2.00
- da € 2.00 a € 4.00
- da € 4.00 a € 6.00
- da € 6.00 a € 10.00
- da € 10.00 a € 20.00
- da € 0.00 in su